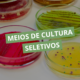

Medição da sudorese e perda de fluidos
A regulação do equilíbrio hídrico é um dos pilares da fisiologia do exercício, diretamente ligada à performance física e à segurança durante a prática esportiva. A sudorese é o principal mecanismo de dissipação de calor, permitindo a manutenção da temperatura corporal durante esforços intensos ou prolongados.
O monitoramento da perda de fluidos é essencial para compreender os efeitos da desidratação, planejar estratégias de reposição hídrica e avaliar os impactos fisiológicos do exercício em diferentes condições ambientais.
Sudorese: mecanismo fisiológico
A sudorese é um processo ativo de secreção de água e eletrólitos pelas glândulas sudoríparas, controlado principalmente pelo sistema nervoso simpático em resposta ao aumento da temperatura corporal. Sua função principal é a termorregulação, mas também influencia:
- Equilíbrio eletrolítico: principalmente sódio e potássio.
- Pressão sanguínea e volume plasmático: perdas excessivas podem reduzir o débito cardíaco.
- Metabolismo muscular: a eficiência da contração pode ser afetada por alterações osmóticas.
A taxa de sudorese varia conforme intensidade do exercício, temperatura e umidade do ambiente, condição física do indivíduo e fatores genéticos.
Importância da medição da perda de fluidos
A quantificação da sudorese permite avaliar a magnitude da desidratação e sua relação com o desempenho físico. Perdas de água superiores a 2% do peso corporal já podem comprometer:
- desempenho aeróbico e anaeróbico;
- percepção de esforço;
- capacidade de regulação térmica;
- função cardiovascular e renal.
A medição precisa é fundamental para o desenvolvimento de protocolos individualizados de reposição hídrica, prevenindo fadiga precoce e riscos à saúde.
Métodos de medição em laboratório
Existem diferentes técnicas para monitorar a sudorese e perda de fluidos, com diferentes níveis de precisão:
1. Pesagem pré e pós-exercício
- Método mais utilizado e direto.
- Consiste em medir o peso corporal antes e após o exercício, considerando ingestão de líquidos e eliminação urinária.
- Permite calcular perda total de fluidos e taxa de sudorese em L/h.
2. Coleta do suor
- Utiliza panos absorventes, cápsulas ou patches colocados em regiões específicas do corpo.
- Permite análise de composição eletrolítica (Na⁺, K⁺, Cl⁻) e identificação de desequilíbrios.
3. Monitoramento contínuo
- Sensores ou sistemas de fluxo de sudorese podem fornecer dados em tempo real durante o exercício.
- Útil em pesquisas sobre fisiologia do desempenho em diferentes condições ambientais.
4. Análise indireta
- Avaliação do volume plasmático e osmolaridade sanguínea para estimar perda hídrica total.
- Combinada com outros marcadores laboratoriais, fornece visão integrada da desidratação.
Aplicações práticas da medição
A quantificação da sudorese tem ampla aplicação em laboratórios de fisiologia do exercício e na preparação física:
- Planejamento de reposição hídrica personalizada: determina volume e composição ideal de líquidos durante treinos e competições.
- Avaliação de risco de desidratação: em atletas de endurance, esportes coletivos e condições de calor intenso.
- Estudo da eficiência termorregulatória: monitoramento de adaptações ao treino, aclimatação a calor ou altitude.
- Pesquisa em performance esportiva: análise do impacto da hidratação na fadiga, rendimento e recuperação muscular.
A medição da sudorese e da perda de fluidos é essencial para compreender o equilíbrio hídrico durante o exercício e sua relação com o desempenho físico. Técnicas laboratoriais permitem quantificar não apenas a perda de água, mas também alterações eletrolíticas que podem impactar a função cardiovascular, muscular e termorregulatória.
O conhecimento detalhado desses processos fornece base científica para estratégias de hidratação individualizadas, prevenindo prejuízos à performance e promovendo segurança durante treinos e competições.
Entre para a lista de espera da Plataforma Cursau e tenha acesso a conteúdos exclusivos de fisiologia do esporte, com análises laboratoriais, desempenho físico e hidratação, integrando o conhecimento com outras áreas da saúde.